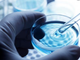
Acqua non potabile e malori: sui social divampa la polemica

Archivio 24 Ore
venerdì 13 marzo
giovedì 12 marzo
Che tempo fa
Rubriche
24 Ore | martedì 20 agosto
(h. 13:13)
Proseguono gli accertamenti dopo i numerosi casi di gastroenterite.
(h. 09:14)
Le prime analisi escluderebbero una correlazione; si aspettano le analisi Asl